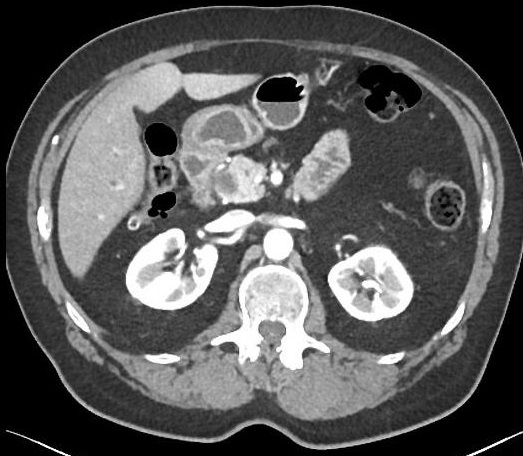

|
Pathologie radiologique de voie biliaire principale
( VBP ) et intrahepatique (VBIH ) : canal hepatique , canal choledoque ...
Tumeur de
voie biliaire :
Dr Bui Binh Tho Tumeur
benigne de voie biliaire :
Les tumeurs benignes des voies biliaire sont
beaucoup plus rare que les tumeurs benignes de la
vesicule biliaire . Il est en plus difficile de diagnostic differentiel avec
de autre pathologie lithiasique ou les lesions malignes de voie biliaire . Cliniquement
c' est
une symptomatologie en rapport avec l'obtruction de
voie biliaire : douleur epigastrique , fievre ,
ictere de cholestase ... La presentation
radiologique des tumeurs benignes des voies
biliaires est souvent commune : Proliferation tissulaire intra-canalaire et une dilatation des
voies biliaires en amont ... Les lesions le plus
frequemment de tumeur benigne de voie biliaire sont :
Les adenomes , la papillomatose biliaire , les cystadenome et rarement les schwanomes ...
- Adenome des voies biliaires
: C'est une lesion polypoide touchant
frequemment de voie biliaire principale , le canal
cystique et puis les voies biliaires intrahepatiques . La
presentation echographique , TDM , IRM et cholangio -IRM retrouve un
polyp intraluminal de voie biliaire de caracter
suivant :
contour lisse , aspect lobulaire dans les formes tubulaires et
crenele dans les formes papillaires
| |
 |
|
 |
|
| |
Aspect
echographique de moindre echogenicite et non
homogene d'une lesion polypoide a bord lisse intraluminal de voie
biliaire ( fleche jaune ) voie biliaire en amont est legerement dilatee .
Image de suggestion de adenome de voie biliaire
, . |
|
Image radiologique TDM a
isodense d'une
adenome de voie biliaire
principale du foie . Voie biliaire intra et
extrahepatique en amont est dilate . Coupe axiale
TDM de l'abdomen avec de contrast intraveineuse |
|
| |
 |
|
 |
|
| |
Image de
dilatation des voies biliaires intra et
extrahepatiques en amont avec aspect d'une osbtacle
hypo-intense arrondie dans voie biliaire principale
. Coupe axiale IRM ponderation T2 |
|
Image radiologique
cholangio -IRM a recontruction en 3D d'une adenome
biliaire . Adenome se retrouve comme une lacune
polipoide a sessile du canal choledoque . Legerement
dilate des voie biliaire en amont . |
|
- Papillomatose des voies
biliaires :
| |
Elle est definie par des
adenomes papillaire multiple de voie biliaire
frequemment sur voie biliaire extrahepatique . Sex ratio
est 1/1 et le plus souvent de 50 - 60 ans . Les lesions
multiples avaient plusieure de risque de degenerescence
maligne que les lesions isoles |
|
| |
Echographie retrouve
des lesions polypoide etagees isoechogene ,
imobilisation , sans cone de l'ombre ascoustique
posterieure et en association de image de dilatation des
voies biliaires en amont . |
|
| |
La TDM , c'est l'absence de
rehaussement de contrst tissulaire . Aspect IRM n'est
pas specifique , c'est image des masses hyposignal T1 et
hypersignal T2 . Sa rehaussement est moin intense que la
parenchyme hepatique apres injection de gadolinium
intraveineuse |
|
| |
 |
|
 |
|
| |
Aspect
echographique des lesions polypoides etagees a
isoechogene non homogene situe
intraluminal de voie biliaire . Image
echographique percutanee du foie . |
|
Image radiologique TDM plus
de C+ en coupe axiale d'une papilome de voie
biliaire . Aspect radiologique est une lesion hypodense a bord
lisse du foie droit ( fleche rouge ) .Dilatation
segmentaire des voies biliaires intra hepatique |
|
| |
 |
|
 |
|
| |
Image radiologique IRM
ponderation T1 d'une papillome de voie biliaire en
coupe frontale avec gadolinium intraveineuse .
Aspect de moindre de rehaussement que la parenchyme
hepatique d'une papillome de voie biliaire
principale ( fleche rouge ) apres injection
gadolinium intraveineuse . |
|
Image cholangio -IRM ,
recontruction en 3D d'une papilomatose
multifocale de voie biliaire ( 3D MRCP ) . Les
lesions papilomatoses etagees dans des voies
biliaire extra et intrahepatique centrale .
Dilatation des voies biliaires en amont et la
cholestase sont tres marquee . Transplantation
du foie est le traitement de choix |
|
- Cystadenome biliaire
:
| |
Tumeur est rare survenant le plus souvent
chez la femme d'age moyen C'est une tumeur
multikystique de taille varie de 3 -40cm , contour bien limite et sa contenue est variable : Sereuse ,
mucineuse , biliaire , hemorragie ou mixte . Siegent le
plus souvent sur voie biliaire intrahepatique |
|
| |
Image echographique est une masse kystique
intrahepatique a septal et a bien limite , echogenecite
de cette kyste est varie selon de sa composition .Il y avait
un cone d'ombre posterieure en cas de
presence de calcification |
|
| |
La TDM peut identifie sa nature
de certaine kyste et apres de injection de
contrast intraveineuse , la rehaussement de la
paroi , des septal kystique sont habituel et les
nodules parietaux ou des bourgeons papillaires
intrakystique doit etre rechercher |
|
| |
Le signal IRM du kyste est varie en
ponderation T1 et T2 |
|
| |
 |
|
 |
|
| |
Image
echographique d'une cystadenome biliaire : Aspect
echographioque est une masse hypoechogene de
contour bien limite avec des septal hyperechoriche
intrakystique . Image de calcifie du cyste est
encore de se retrouve |
|
Image d'une masse a
volumineuse hypodense a contour lisse avec septal intrakystique et calcifie du foie droit peut en voyant . Image
radiologique TDM de l'abdomen en coupe axiale |
|
| |
 |
|
 |
|
| |
Meme cas
en coupe TDM codonal |
|
Diagnostic radiologie
differentiel le plus souvent est : Kyste hydatique
du foie ( image sup ) , abces du foie ( image
inferieure ) et kyste simple du foie . |
|
- Schwanome biliaire :
C'est une tumeur neurofibromatose type I a
partir de fibre nerveuse sympathique et
parasymphatique ratache au voie biliaire et a la
vesicule . Presentation echographique est sous
forme polyp intraluminal ou nodules muraux
isoechogene de voie biliaire intra et
extrahepatique . La TDM revele une masse
hypodense , partiellement calcifie ou kystisee ,
rehaussement heterogene apres injection de
contrast intraveineuse . Aspect IRM est resemble
les autres schwanomes : hyposignal T1 ,
hypersignal T2 et rehaussement heterogen apres
injection de contrast intraveineuse et
heterogene du gadolinium . Tumeur est tres rare
..
Diagnostic radiologie differentiel :
- Kyste simple du foie :
- Kyste hydatique ( echinococcus cyst )
- Abces du foie
Tumeur maligne de
voie biliaire :
Cholangiocarcinome ( CHK
) : C'est une tumeur maligne origine des
cholangiocyte de voie biliaire avec de prognostic
mauvaise , se proliferation sous forme exophytique
infiltration pericanalaire ou endocanalaire . Sa incidence
est pres de 3% des cancer gastro-intestinaux et de 10-15%
des tumeur malignes hepatobiliaire , predominance le
plus souvent sur l' homme entre 50 - 70ans . L'etiologie de
CHK est encore meconnue mais plusieure des facteurs de
risques cholagiocarcinnogenesis ont establissement,, le
tableaux suivant donne les facteur de cholangiogenesis
:
| |
Facteurs de risques
etablissement : |
|
Facteur de risque probable |
| |
- Cholangite slerosant primitive
- Parasite hepatobilisaire
- Cholelithiasis
- Syndrome de Caroli
- Kyst choledocal
- Thorotrast
|
|
- Cirrhose du foie
- HBV
- HCV
- Diabete mellitus
- Obesite
- Alcolism
- Toxin ( dioxine , polyvinyl chloride )
|
| |
Aspect radiologique de cholagiocarcinome
biliaire ( CHK) dependent du siege au niveau de l'arbre biliaire
et du type de infiltration : |
|
| |
Selon
la localisation sur l'arbre biliaire
cholangiocarcinome biliaire peut en siegant :
Cholangiocarcinome intrahepatique peripherique ( 15% )
, cholangiocarcinome hilaire : tumeur de Klatskin ( 60% ) et
cholagiocarcinome de voie biliaire principale (25%) |
|
| |
 |
|
Classification des
cholangiocarcinomes selon leur localisation
sur l'arbre biliaire :
- 1 - Cholangiocarcinome
peripherique intrahepatique ( 15%)
- 2 - Cholangiocarcinome
hilaire :
tumeur de Klatskin ( 60%)
- 3 - Cholangiocarcinome de la voie
biliaire principale ( 25% )
|
|
| |
|
|
|
|
Selon de type d' infiltrative on peut en classifie
: Infiltration en forme de masse , le plus souvent dans le
CHK intra-hepatique . Infiltration pericanalaire est
frequemment dans les CHK perihilaire extrahepatique ;
Infiltration endocanalaire est plus rare .
| |
Classification des
cholangiocarcinomes selon de type de infiltration :
- 1 - Proliferation sous forme une
masse : Frequemment dans le CHK intrahepatique
- 2 - Infiltration pericanalaire :
Souvent dans les CHK peri-hilaire et extra-hepatique
- 3 - Infiltration endocanalaire : Plus
rare
|
|
 |
|
| |
|
|
|
|
Image echographique
per cutanees : Images echographique d'une
cholangio-carciome biliaire intra-hepatique est une
masse
hypo , hyperechogene , heterogene , polylobee hypo-vascularisation
; dilatation des voies biliaire en amonrt est frequemment .
Sur les tumeur
peri-canalaires image de dilatation de
voie biliaire est toujour bien de detecter mais la
lesion pericanalaire est moin de retrouve . Dans type infiltration endocanalaire
image echographie d'une formation non homogene , irregulier
et obstructive la lumiere avec dilatation important de
voie biliaire en amont est en se retrouve
| |
 |
|
 |
|
| |
Aspect echographique d'une
cholagiocarcinoma de voie biliaire intrahepatique
est une masse non homogene hypoechoriche polylobee
du foie . Dilatation des voie biliare segmentaire en
amont est tres marquee . |
|
Meme cas en meme coupe : La
lesion est un masse a hypo vascularisation . Les
flux Doppler en couleur des vaisseaux hepatique
se retrouve tres net |
|
| |
 |
|
 |
|
| |
Dilatation de voie
biliaire intrahepatique d'une cholangiocarcinoma
biliaire . Image echographie en Doppler a couleur du
foie . |
|
Cholangicarcinoma biliaire
forme pericanalaire ( fleche jaune ) . Voie biliaire
en amonrt est tres dilate . Image echographie
percutanee en coupe hypochondre droit |
|
| |
 |
|
 |
|
| |
Aspect echographique d'une
cholangiocarcinoma de type pericanalaire situe a la
bifurcation de voie biliaire principale . Tumeur de
Klastkin , voie biliaire intra hepatique est dilate |
|
Même cas en coupe
echographie avec Doppler a couleur . Image de
voie biliaire dilate n'a pas de flux sanguine . |
|
Image radiologique TDM
: Aspect TDM d'une cholangiocarcinoma de
voire biliaire ( CHK ) intra hepatique est une
masse a hypodense ou isodense polylobee , non
encapsulee , rehaussement tardive et pas de wash-out portal
sont des signes radiologiques retrouves. Parfois a possible
on peut retrouve des nodules de satelite
intrahepatique et image de dilatation de voie biliaire en
amont est frequemment . Les lesions d'
infiltration pericanalaire image radiologique
retrouve est epaissiement
parietale et irregulie des voie biliaire avec
de rehaussement tardive lesionaire . Dilatation des voies
biliaires en amont est marquee . Aspect radiologique des infiltrations endo-canalaire
est une lesion tissulaire endo -luminal de hypodense de voie
biliaire principale . Dilatation voie biliaire en amont
est important
| |
 |
|
 |
|
| |
Aspect radiologique TDM du
cholangiocarcinoma biliaire type infiltration en
masse intrahepatique : Image masse hypodense
multiple non capsularite et polylobe du foie droit .
Voie biliaire intrahepatique en amont est dilate ..
Image TDM avec contrast intraveineuse phase arteriel
en coupe axiale |
|
Une autre cas de
cholangiocarcinoma biliaire intrahepatique du foie
droit : Aspect de masse hypodense polylobe
situe au foie droit avec image de rehaussement
tardif . Plusieur de nodule satelite peut en
voyant . Image radiologique TDM plus contrast
intraveineuse phase veineuse |
|
| |
 |
|
 |
|
| |
Aspect radiologique a
hypodense a bord irregulie d'une cholangiocarcinoma
de la base choledoque au tete du pancreas |
|
Même cas en coupe plus haute
a traverse canal hepatique commune . Ce voie
biliaire est tres dilate et voies biliaires
intrahepatique se retrouve legerement dailate .
Image TDM plus contrast intraveineuse ( arteriel
phase ) coupe axiale . |
|
| |
|
|
|
|
Image IRM et
cholangio-IRM : Image IRM d'une
cholangiocarcinome biliaire intrahepatique est
une masse polylobee , non en capsulee hyposignal T1 , hyper
ou iso signal T2 avec une centre plus hypointense , rehaussement tardif
est signe specifique pour diagnotic . Lesion de type pericanalaire donne
image de epaissisement parietale irregulier de voie
biliaire avec rehausement tradif du lesion et dilatation marquee en
amont . Sur lesion de type endocanalaire , image
cholangio-IRM est lesion tissulaire endo-luminale.avec
stenose et dilatation en amont tres marquee . Cholagio -IRM
donne de image global tres nette de voie biliaire et de la
lesion .
| |
 |
|
 |
|
| |
Cholangiocarcinoma
intrahepatique du foie droit .Lesion est une masse
hyposignal polylobee a moindre limite situe au
segment V , VIII du foie droit . Image radiologique
IRM ponderation T1 en coupe axiale . |
|
Même cas en coupe axiale IRM
ponderationT2 . Image du lesion est legerement
hyperintense . Voies biliaies du foie droit sont
tres hypersignal et dilate |
|
| |
 |
|
 |
|
| |
Masse de lesion
cholangicarcinoma du foie droit . Lesion polylobee hypersignal avec centre de tres hypointense .Dilatation
de voie biliaire droit est marquée . Image
radiologique IRM ponderation T2 ,
coupe axiale |
|
Tumeur cholangiocarcinome pericanalaire
hilaire de type Klastkin , lesion en proliferation a
gauche . Voies biliaire est dilate en accentuation
au foie gauche . Image radiologique IRM ponderation
T2 en coupe axiale . |
|
| |
 |
|
 |
|
| |
Aspect
radiologique d'une cholagiocarcinoma pericanalaire
de la VBP . Voie biliaire en amont est dilate . Image radiologique cholangio -IRM
recontruites en 3D : |
|
Image radiologique cholangio -IRM
recontruites en 2D : Aspect radiologique d'une
cholagio - carcinoma endocanalaire , infiltration
tissulaire en bourgeon endocanalaire au bas du canal
choledoque . Voie biliaire en amont est tres dilate |
|
| |
 |
|
Aspect radiologique tres nette d'une
cholangio-carcinoma pericanalaire hilaire ,
tumeur de Klastkin
stade II . Image radiologique ERCP |
|
Diagnostic
radiologique differentiel :
- Metastase du
foie : Nodule hypodense multiple du foie (TDM) . Necrose
central avec hypersignal T2 central
- Hepatocellule carcinoma ( HCC) : Aspect
resemble , souvent encapsulé et presence de thrombus
vieneuse
- Abces du foie
- Hepatolithiase , calcul de voie biliaire principale
.
- Cystadenome biliaire
- Tumeur de la tête du pancreas
Metastase endobiliaire
:
C'est la lesion metastasique par extension
endobiliaire d'un HCC ou lesion bourgeonaise neoplasique
endobiliaire d'un adenocarcinome vesiculaire .Ca peut etre
de adenome- carcinome colorectal ou le plus souvent de
melanome . Image radiologique TDM est lesion seul ou
multiple a hypodense . Dilatation segmentaire en amont
peut se retrouve . Aspect IRM est lesions de
developement endocanalaire en hypersignal T2 et dilatation
segmentaire des voies biliaires intrahepatiques . L'etat
generale du maladie a ce stade le plus souvent alteree vers
en cachexie
| |
 |
|
 |
|
| |
Image radiologique
TDM plus C+ coupe axiale du
metastase endobiliaire d'une
adenocarcinome rectal . Lesion multiple
hypodense du foie droit ( fleche rouge )
avec dilatation segmentaire des voie
biliaire . |
|
Lesion metastasique
endobiliaire hypersignal du foie droit (
fleche rouge ) . Image IRM ponderation
T2 en coupe axiale |
|
| |
 |
|
Image radiologique d'une
metastase endobiliaire de la VBP pres de
bifurcation biliaire du hile du foie .
L'obstacle un peut plus serré sur la branche
gauche du canal biliaire , dilatation de
voie biliaire gauche en amont est tres
marquée.Cholangio IRM de voie biliaire d'une
maladie adenocarcinome colique avec
alteration de l'etat generale et cholestase
biologique |
|
| |
|
|
|
|
Dr Bui Binh Tho
Page :
1
/
2
/
3
/
4
/
5
/
6
/7/
8/
9
/
10
/11/
12 A
suivre
<<
PREVIOUS
<<
>> NEXT >>
,
|
|